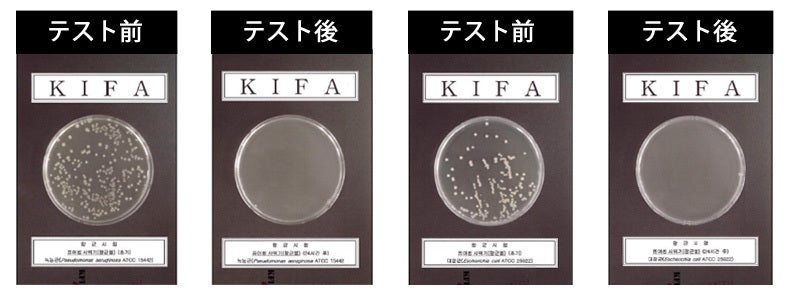

水道水の残留塩素の除去ができないか?
水道水に含まれる不純物を除去し、目で確認することができないか?
長い間使うものだから、浄水フィルターを安く購入できないのか?

MARIN PEOPLE株式会社は、これまで海外メーカー製品を輸入販売を中心としておりましたが、これまで満足の出来る機能の備わったシャワーヘッドが無いと感じた為、1年間の時間を費やし、設計及びデザインを一貫して行い、ついに自社製品である「スエニーシャワーヘッド」を製作致しました。
残留塩素除去、さび、不純物除去、浄水、節水効果、抗菌、安全性、浄水で使用するフィルター、そのフィルターを低価格で購入できる、破損しにくい製品、優れたデザイン性など全ての機能を一つにしました。


洗浄できない地中の水道管
水道水が運ばれてくる水道管は時間が経つほど、不純物と水道管の腐食で多くの汚染物質が配管の中に接着していきます(特に古い水道管の場合)。
水は透明ですが、家の環境によって微細に緑水や不純物が一緒に出ている可能性があります。
RoHS認証されたマイクロセジメントフィルターを使用しています。
RoHS認証とは特定有害物質使用制限をするもので、EU(欧州連合)域内において、コンピュータ、通信機器、家電等の電気・電子機器について有害な化学物質の使用を禁止する指令です。
このフィルターは浄水器の粒子が大きいほこり、サビ、砂、土などをろ過します。
粒子の大きい沈殿物が他のフィルターに流入することを防ぎ、主にフィルターの最初の部分に取り付けられるため、前処理フィルターと呼ばれています。
プロダクト誕生・プロジェクト立ち上げの背景や経緯を具体的に書きましょう。
↓不純物テストのためにインクを入れてテストしました。


錆水、不純物によるフィルター汚染の変化です。 東京羽田近くの家庭で実験を行いました。
※フィルター汚染の変化は地域によって異なる場合もございます。


3段階トータルフィルターに付いている塩素ボールは、肌に負担を掛けにくくする為、水道水の残留塩素をより毒性のない水に浄化しようとする働きを持ちます。 この塩素ボールは時間が経てば溶ける特徴があり交換が必要となります。
3段階トータルフィルター付きシャワーヘッドは弊社で開発した特殊な塩素ボール付き除去フィルターを使用。
特定試薬O-T試薬(O-Tolidine solution)残留塩素(CL)測定試薬テスト1
1.カップに水道水を入れます。
2.水道水にO-T試薬を入れます。
3.黄色に変わりする水道水

水道水は汚染された水を様々な浄化段階を経て家庭に到着します。
浄水場でろ過、殺菌、消毒し、水道水として供給しています。この浄水場から流れてくる水道水には各家庭に無菌状態で届けるために、残留性のある塩素が入っています。この塩素濃度は1PPM~2PPMとも言われています。

特定試薬O-T試薬(O-Tolidine solution)残留塩素(CL)測定試薬テスト2

シャワーヘッドのヘッドに抗菌力を持つ白色の粉末に銀と混ぜた後、無機抗菌剤を噴射して作られたセラミックボールを取り付けました。
抗菌ボールは細菌とカビなどの繁殖を抑制します。水の臭いを除去するのに効果的です。
浄水器、軟水器などのフィルター、医療器洗浄などに使用されたりしています。

抗菌ボールテスト成績書 / 各種菌テストの結果
抗菌ボールテスト成績書 / 各種菌テストの結果

 このステンレス微細孔散水板は、独自のデザインで強力な水圧と広々とした柔らかな水の流れを作り、心地よい水流を感じることができます。
このステンレス微細孔散水板は、独自のデザインで強力な水圧と広々とした柔らかな水の流れを作り、心地よい水流を感じることができます。



シャワーヘッドの短所は、ヘッドとハンドル部分が折れるやすい場合があることです。
いつものシャワー後にシャワーヘッドの中に水が残っており、少し重い状態で落下した際に破損することがあります。
スエニーシャワーヘッドは独自の金型設計で、折れにくいデザインを設計しました。 フィルターだけ交換すれば長く使用することができます。
沖縄リゾートホテル付き写真
沖縄の水道水は水道の直水配管ではなく、水槽から流れて家に流入する方式で、水槽内に汚染と石灰成分が多く含まれています。
その間、沖縄、東京、ソウル、上海でテストを繰り返して完成しました。





Q . 2段フィルターと3段トータルフィルターの違いは?
2段フィルターは錆水と不純物、ほこりなど老朽化した配管の粒子性物質を濾過します。
3段トータルフィルターは、弊社で独自に開発したROHS認証フィルターで水道水の塩素除去、錆水と不純物、ほこりなどオールインワントータルフィルターです。
Q . フィルター使用期間は?
弊社では60日から70日間の使用を推奨しています。 しかし、使用環境や汚染によって30日程で使用する場合もございます。
Q . サイズが合わないので、交換は可能ですか?
申し訳ありません。サイズが合わない等の理由での交換は不可の為、予めサイズをお確かめの上ご購入ください。
また、サイズ変更のアダプターは市販されておりますシャワーヘッドアダプターで対応出来るかと思いますので、お買い求めください。
Q . 破損しました。交換は可能ですか?
1年以内に破損した場合、新しいものに交換可能です。(破損製品を弊社までお送りください。)

集まった資金は服、下着、スポーツウェアなど今後の製品生産の展開に充てさせていただきます。また、老人福祉施設やお年寄りのためのマットレス、防水カバーおよびマット等などの製品を製作も予定しております。
製造工場 : Su & Tech
事業内容 : シャワーヘッドOEM生産
製造会社の紹介
シャワーヘッド専門企業で、代表はシャワーヘッドの製作技術者に18年在職後、2014年に会社を設立、現在OEM生産で中南米、欧州、豪州に輸出しています。
【製造企画販売会社】
輸入販売元 : MARIN PEOPLE株式会社
本社所在地 : 〒144-0034東京都大田区西糀谷4-26-3メゾンHAYASHI202号
Fax: 03-6423-9952
事業内容 : 輸出・輸入・販売・卸し等
ノウハウと効率的に構築されたシステムに基づいて、現在、自社オリジナルブランド製品と国内外の製品を販売しています。海外のニュートレンド製品の輸入から、日本企業のオリジナルブランドの商品企画、生産、輸出までを行っています。新しいトレンドをお届けし、より豊かな生活を送っていただくため日々努力しています。
リスク&チャレンジ
※使用感などに関しては、感じ方に個人差が予想される製品でございます。そのため、使用感等に関する返品・返金はお受けいたしかねます。 ※生産状況・天候・配送問題などで、輸送が遅延する可能性がございますので、ご留意ください。 上記のようにブロジェクトベージに記している内容に変更がある場合は、できるだけ早く活動レボ ートなどで共有を行なっていく予定です。 ※製造委託先の技術を使用し、製造された製品になりますので、類似品が販売される可能性がございます、予めご了承いただけますと幸いです。 クラウドファンディングの性質上、以上の注意点につきましてあらかじめご理解とご了承いただいた上でご支援くださいますよう、よろしくお願い申し上げます。 最後に、本製品を手に取った皆様に喜んでもうえるよう、 チームメンバー一同心を込めて対応していきますので、 応援よろしくお願い致します。
















コメント
もっと見る